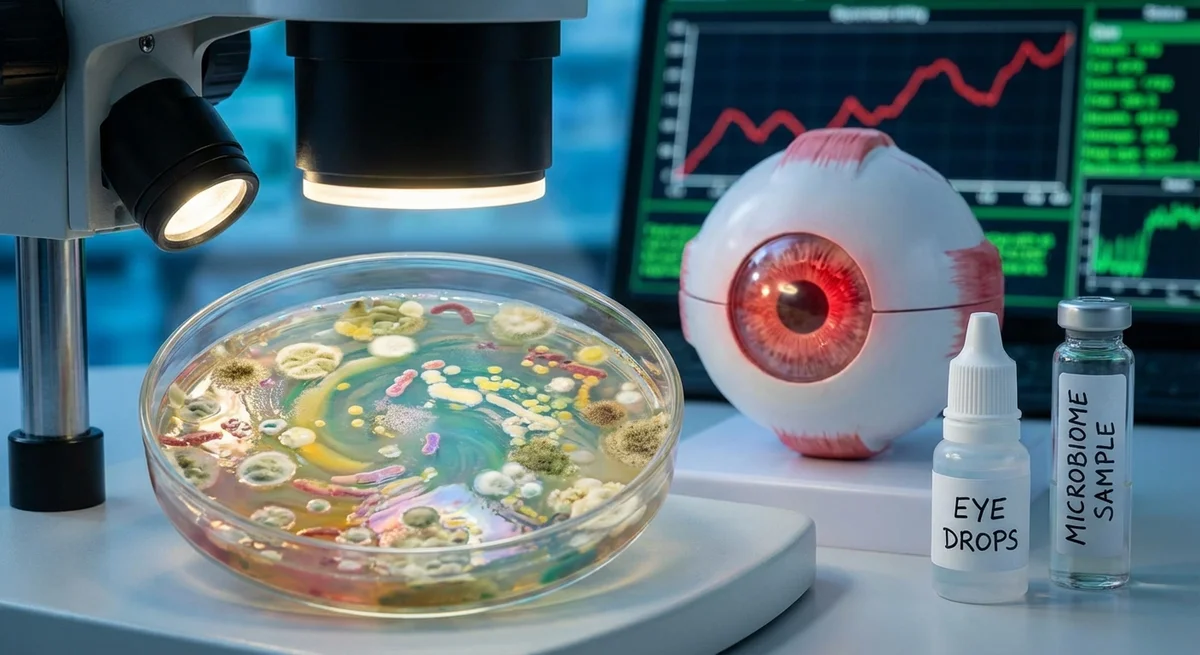
The Ocular Microbiome, Inflammaging, and Surface Health

Introduction
Our eyes are covered by a thin film of tears and a community of harmless microbes – the ocular surface microbiome – that help protect them. This microbiome normally lives in balance, but as we age the balance shifts. Aging brings a chronic, low-level inflammation (often called “inflammaging” (pmc.ncbi.nlm.nih.gov)) which can affect all tissues, including the eyes. The result is a higher risk of conditions like dry eye and meibomian gland dysfunction (MGD) – where the oil glands in the eyelids don’t work well. These conditions cause tear film instability and irritation. In recent years, researchers have found that age-related changes in the eye’s microbial community are linked to this inflammation and surface disease. Understanding these changes is important for keeping older eyes healthy.
For example, a study of healthy volunteers found that tears and eyelid bacteria became “more inflammatory” with age – older people had higher levels of inflammatory molecules (like ICAM-1 and IL-8) on the conjunctiva after age 60 (pubmed.ncbi.nlm.nih.gov). Over the years older eyes often make fewer and thinner tears (pubmed.ncbi.nlm.nih.gov) and blink less, which may let more irritants and microbes accumulate. At the same time, enzymes and toxins from certain eyelid bacteria (e.g. Staphylococcus aureus) can stimulate inflammation and damage the tear film (pmc.ncbi.nlm.nih.gov) (pmc.ncbi.nlm.nih.gov). In a combined effect, an aged ocular surface can become chronically irritated.
Recent studies confirm that the mix of microbes on the eye changes with age. Using DNA sequencing, scientists showed that “young” and “old” adult eyes have different bacterial communities and gene functions (pubmed.ncbi.nlm.nih.gov). In other words, growing older appears to reshape which bacteria thrive on the eye. These shifts seem to favor some types of microbes that can make inflammation worse. (Older patients often also use eye drops for conditions like glaucoma; those drops – especially if they contain preservatives – further alter the ocular flora (pmc.ncbi.nlm.nih.gov).) In short, aging eyes often show microbial changes that go along with a tired tear film and low-grade eyelid inflammation.
Age-Related Microbiome Changes and Ocular Surface Inflammation
Dry Eye and Meibomian Gland Dysfunction (MGD)
Dry eye disease (DED) is very common in older adults. It happens when the tears can no longer keep the eye surface wet and nourished. DED has two major forms: one where the tear glands make too little water, and another where tears evaporate too quickly (often because of poor oil quality). The oil layer of tears comes from the meibomian glands in the eyelids. As people age, these glands more often become blocked or change their normal oil composition. This meibomian gland dysfunction (MGD) leads to very oily tears or no oil at all, making eyes dry and inflamed. In fact, about 70% of dry eye patients have MGD (pmc.ncbi.nlm.nih.gov).
Recent research has found that the bacteria living in and around the meibomian glands are different in MGD. Shotgun DNA sequencing of meibum (the gland oil) showed that people with MGD have a “distinct microbiota” in their eyelid secretions (pmc.ncbi.nlm.nih.gov). For example, potentially harmful bacteria like Campylobacter coli, Campylobacter jejuni, and Enterococcus faecium were abundant in MGD glands but nearly absent in healthy controls (pmc.ncbi.nlm.nih.gov). These bacteria carry genes for strong virulence factors (such as immune-evasion proteins and secretion systems) that could fuel chronic eyelid inflammation (pmc.ncbi.nlm.nih.gov). In contrast, healthy meibum mostly contained common skin bacteria like Staphylococcus epidermidis. Other studies found that coagulase-negative staphylococci and Corynebacterium are commonly associated with dry eye and MGD (pmc.ncbi.nlm.nih.gov) (pmc.ncbi.nlm.nih.gov). In short, blocked, stagnant gland oil in older eyes may feed undesirable microbes, which in turn may worsen tear film quality and eyelid inflammation.
Dry eye itself also correlates with lower microbial diversity on the eye. One review reports that patients with severe aqueous-deficient dry eye (like Sjögren’s syndrome) have significantly fewer different bacteria on the eye surface than healthy people (pmc.ncbi.nlm.nih.gov). In general, normal eyes tend to be kept clean by tears and antimicrobial proteins. But in dry eye, damage to the surface and changes in gel-like mucins allow different bacteria to stick or grow more easily. For example, researchers found that people with dry eye had reduced amounts of Proteobacteria (a common phylum in healthy eyes) and Pseudomonas, and relatively more Gram-positive bacteria (like Staphylococcus) (pmc.ncbi.nlm.nih.gov). These shifts may further stimulate inflammation and slow healing.
Inflammaging and Ocular Immunity
Aging is marked by inflammaging – a persistent, low-level inflammation throughout the body (pmc.ncbi.nlm.nih.gov). This state raises inflammatory signals even in healthy tissues. On the ocular surface, this means older eyes tend to have a tougher time controlling irritation. For example, a study of volunteers grouped by age (young: 19–40, middle: 41–60, older: 61–93) showed that dry eye signs and inflammatory markers steadily increased with age (pubmed.ncbi.nlm.nih.gov). The tear film became less stable (tear break-up time dropped from ~11s in young to ~9s in older) and tear volume shrank (pubmed.ncbi.nlm.nih.gov). At the same time, conjunctival cells made more inflammation-related proteins (ICAM-1 and IL-8) in older subjects (pubmed.ncbi.nlm.nih.gov). Women reported higher dry eye symptoms on average, but the age trend applied to all. These findings demonstrate that a clinically healthy older eye already shows more inflammation and worse lubrication than a young eye.
The changes in the microbiome seem linked to this ocular inflammaging. Normally, certain resident bacteria help maintain a healthy immune balance. For instance, in mice a commensal Corynebacterium on the eye surface stimulates local T cells to secrete IL-17, which then boosts production of antimicrobial factors in tears (pmc.ncbi.nlm.nih.gov). This keeps nasty invaders (like Pseudomonas or fungal Candida) at bay. Similarly, germ-free mice (raised with no microbes) have weaker corneal barriers and far fewer tear antibodies (IgA) than normal mice (pmc.ncbi.nlm.nih.gov). In short, a healthy microbiome actually trains the eye’s front-line defenses. But if the microbiome is depleted or skewed (for example by aging or over-cleaning), the defenses falter and chronic inflammation can take hold.
In older eyes with dry eye or MGD, the microbial shift seems to favor inflammation. Gram-negative bacteria make lipopolysaccharides (LPS) that trigger Toll-like receptors, driving inflammation. In fact, Chang et al. found that glaucoma patients using preservative drops (often older adults) had a bloom of diverse gram-negative bacteria on their eyes (pmc.ncbi.nlm.nih.gov). Their treated eyes’ microbiome had high predicted LPS synthesis. This correlated with a lower tear meniscus height and shorter tear break-up time (pmc.ncbi.nlm.nih.gov) (pmc.ncbi.nlm.nih.gov). In plainer terms, eyes with more of these bacteria had drier surface measurements and more inflammation markers. Indeed, glaucoma patients often report burning and tearing from their drops (pmc.ncbi.nlm.nih.gov), and this study suggests part of that effect may be microbiological as well as chemical.
The Glaucoma Patient’s Perspective
Glaucoma is usually an older person’s disease, and its treatment often involves long-term eye drops. Many glaucoma drops contain preservatives (like benzalkonium chloride) that are toxic to surface cells. Large studies have shown that preserved glaucoma drops cause much more eye irritation and dryness than preservative-free versions (pmc.ncbi.nlm.nih.gov). Our review suggests that this worsens the ocular microbiome too. In Chang et al., even the non-treated eye in glaucoma patients showed microbial changes, implying systemic or cross-contamination effects (pmc.ncbi.nlm.nih.gov). Thus, a glaucoma patient may face a compounding cycle: the drops irritate the eye, reducing tear defense, and the resulting microbiome shift then fuels more inflammation. From a patient’s viewpoint, this means extra symptoms and the need for more adjunctive therapies (like tear substitutes and lid treatments).
Microbiome-Targeted Interventions for Surface Health
Because altered microbes may drive inflammation, treatments aimed at “rebalancing” the microbiome are being explored. Here are some evidence-based strategies:
-
Eyelid hygiene: Careful cleaning of the eyelid margins is the first-line approach to blepharitis and MGD. Simple scrubbing with diluted baby shampoo or commercial lid wipes can physically remove debris, oils, and mites. More targeted products include hypochlorous acid (HOCl) wipes. HOCl is a gentle, saline-based antiseptic (sold under brand names like Avenova). Clinical studies show it is safe around the eyes and kills many bacteria. For example, Mencucci et al. found that 4 weeks of twice-daily HOCl cleansing significantly reduced bacterial load on the eyelid compared to gentle saline wipes (pmc.ncbi.nlm.nih.gov). Tear break-up times and symptom scores improved only in the HOCl group. Another trial using HOCl wipes for internal styes (hordeolum) found they dramatically cut staph and Neisseria on the lids, while increasing certain beneficial gut-derived bacteria (like Bifidobacterium and Faecalibacterium) with anti-inflammatory properties (pmc.ncbi.nlm.nih.gov). In short, antiseptic lid cleaning can shift the eyelid microbiome away from pathogens and help reduce inflammation. It is safe for daily use and often recommended wherever blepharitis or MGD is suspected.
-
Thermal therapy (warm compresses): Applying warmth to the eyelids helps unblock hardened oils and restore normal tear lipid. Warm compresses (a hot towel or eye mask at ~40°C for 5–10 minutes) are a cornerstone of MGD management. A recent review of clinical trials confirms that even a single 5–20 minute application can improve tear quality (pmc.ncbi.nlm.nih.gov). Repeated daily use (especially moist heat masks) not only melts the oils but also can soothe inflammation and even reduce Demodex mite load (a microscopic eyelid parasite linked to blepharitis). While heat itself doesn’t add or kill any bacteria directly, by restoring more normal oil flow it helps the eye’s environment favor its natural defenses. A patient repeatedly using warm compresses often notices less grittiness and better moisture.
-
Probiotics and prebiotics: These are “friendly” bacteria or nutrients that support them, taken orally or (in experimental studies) topically. The idea is that a healthy gut microbiome can dampen whole-body inflammation (via the so-called gut–eye axis) and possibly even influence ocular surface microbes. Several small studies hint at benefit. In one randomized controlled trial, dry eye patients took an oral probiotic/prebiotic supplement for 4 months. The treated group’s average symptom score (OSDI) improved significantly compared to placebo (pmc.ncbi.nlm.nih.gov). Tear breakup time and tear volume remained stable in the treatment group but worsened in placebo, suggesting some protection. Other pilots found that probiotic mixtures (for example, Enterococcus faecium and Saccharomyces boulardii) increased tear production and stability in dry eye patients (pmc.ncbi.nlm.nih.gov). Researchers have also tested direct probiotic eye drops: one small trial in allergic conjunctivitis showed Lactobacillus eye drops reduced symptoms compared to no treatment. The evidence is preliminary, but it points toward a role for beneficial microbes. If confirmed, oral probiotics or specially formulated eye drops could someday help re-tune the ocular microbiome or systemic immunity. (At this time, patients should use probiotics for gut health as advised by their doctor; ocular probiotic therapies are experimental.)
-
Antimicrobial / Anti-inflammatory drops: In some cases, doctors prescribe antibiotic ointments (like erythromycin or azithromycin on the lid margins) or short courses of steroid drops to break the cycle of inflammation. These work mainly by killing or suppressing local bacteria and immune cells. They can be effective, but they are a blunt tool – peeling back the entire microbial community. Broad antibiotics may temporarily improve symptoms, but they also wipe out beneficial organisms. For instance, long-term use of antibiotic ointment or steroid drops can make the eye more susceptible to fungal or resistant bacterial overgrowth. Therefore, these are usually short-term solutions while other therapies (like warm compresses or lid hygiene) are started. Patients must also tell doctors about their drops history, as preservative-free formulations can reduce harm.
-
Contact lens and other factors: While not treatments per se, some habits affect the microbiome. Contact lens wear, for example, makes the eye’s flora more skin-like (with more Pseudomonas and Acinetobacter) (pmc.ncbi.nlm.nih.gov), which increases dryness and infection risk. Patients should on occasion remove lenses and use daily cleaners. Excessive eye rubbing or makeup near the eye can also disturb the natural flora. So general ocular hygiene – clean pillowcases, clean hands, avoiding expired makeup – is part of preserving a healthy microbiome.
Challenges in Measuring the Ocular Microbiome
Studying the eye’s microbial community is hard. First, the ocular surface is a low-biomass site – there aren’t many bacteria living on the eye compared to the gut or skin. This means samples (tears or swabs) contain very little DNA. Even a tiny bit of contamination (from the air, skin, or reagents) can overwhelm the true signal (pmc.ncbi.nlm.nih.gov) (pmc.ncbi.nlm.nih.gov). For example, researchers warn that normal cotton swabs can introduce bacteria from the environment. One technical study found that specialized sponge swabs collected more bacterial DNA than cotton or polyester swabs (pmc.ncbi.nlm.nih.gov). Another issue is viability: a swab might pick up dead bacteria fragments that aren’t actually colonizing the eye (pmc.ncbi.nlm.nih.gov).
Different labs use different protocols for sampling. Some gently touch the lower eyelid margin and conjunctiva; others flush the eye with saline and collect fluid. Some studies use topical anesthetic (which could affect bacteria), others do not. Even the room’s humidity or a person’s recent tear drug (like a steroid drop) can change the count. Without standardized methods, results can vary widely. A recent review of ocular microbiome methods concludes that the field urgently needs standardization: agreed ways to collect samples, run controls, and filter out contaminants (pmc.ncbi.nlm.nih.gov) (pmc.ncbi.nlm.nih.gov). For example, every study should include negative controls (blank swabs and extraction reagents) to check for external DNA (pmc.ncbi.nlm.nih.gov). Only then can researchers confidently compare “microbiome profiles” between studies or track changes after an intervention.
In summary, measuring the eye’s microbiome demands extra care. It’s easier to get misleading data than for, say, gut samples. But improved techniques are emerging (for example, whole-genome “shotgun” sequencing, on-site imaging of bacteria, and better bioinformatic tools) that will help validate and reproduce findings.
Towards Lasting Benefits – Research Priorities
We are still at the early stages of translating microbiome science into long-term eye health. Key research goals include:
-
Longitudinal studies: We need large, long-term studies of people as they age to see how their ocular microbiome naturally evolves, and which changes predict eye problems. For instance, tracking a cohort of 100 adults over 20 years could reveal whether certain early microbiome patterns lead to dry eye or meibomian gland disease later. Such studies can also assess how factors like diet, systemic health, or medications (particularly in glaucoma patients) influence the ocular flora over time.
-
Controlled trials of microbiome therapies: The pilot probiotic/prebiotic trials are encouraging, but small. We need larger, well-designed clinical trials to test whether interventions like oral probiotics or formulated eye drops can prevent or reverse ocular surface aging. Trials should include objective outcomes (tear production, corneal health) and patient-reported quality-of-life measures. Similarly, studies could test whether regular hypochlorous lid hygiene in middle-age leads to fewer cases of chronic blepharitis or MGD a decade later. Mechanistic research (e.g. sampling the microbiome before and after an eyelid treatment) should be built into these trials to confirm how the communities shift.
-
Integration with systemic health: The eye does not exist in isolation. There is growing evidence of a gut–eye axis in diseases like uveitis and macular degeneration. We need research connecting ocular surface microbiota with gut and skin microbiomes. For older adults, it would be valuable to know if general anti-aging interventions (good nutrition, exercise, controlling diabetes) that benefit the gut microbiome also help keep eyes healthy. In other words, can we help “upgrade” the ocular surface by improving overall immune and microbial health? Some studies already suggest that fecal microbiota transplants or engineered probiotics can modulate ocular inflammation in animal models. Testing such strategies in the context of age-related ocular disease is a novel direction.
-
Standardized measurement methods: As mentioned, a research priority is establishing common protocols. This includes defining which eye sites to sample (e.g., eyelid margin vs. conjunctiva), what time of day, and how to process samples. International working groups (perhaps under ophthalmology societies) could publish guidelines. They should recommend negative controls and thresholds for calling a sequence a “true” resident microbe. With standard methods, data from different studies will become comparable, accelerating discovery.
-
Healthspan-focused outcomes: Ultimately, we want to know if modulating the microbiome leads to durable improvements in eye comfort and vision. For example, one could study whether older adults practicing daily lid care and taking probiotics maintain better tear film and vision into their 70s, compared to those who do not. Or whether treating early blepharitis aggressively reduces the long-term incidence of corneal damage. We should also watch for unintended effects: wiping out too many microbes might make eyes prone to infection, so research should balance risks and benefits.
In conclusion, the ocular microbiome is a promising frontier in preserving eye surface health as we age. Growing evidence links age-related microbial shifts to chronic inflammation, dry eye, and MGD. Early trials of targeted interventions (lid hygiene, heat therapy, selective antimicrobials, probiotics) show potential to rebalance this ecosystem. However, the field needs more robust trials, better sampling methods, and integration with overall health strategies. If successful, future treatments could help extend the quality of vision and comfort for seniors – keeping the “magic eye camera” rolling smoothly well into old age.